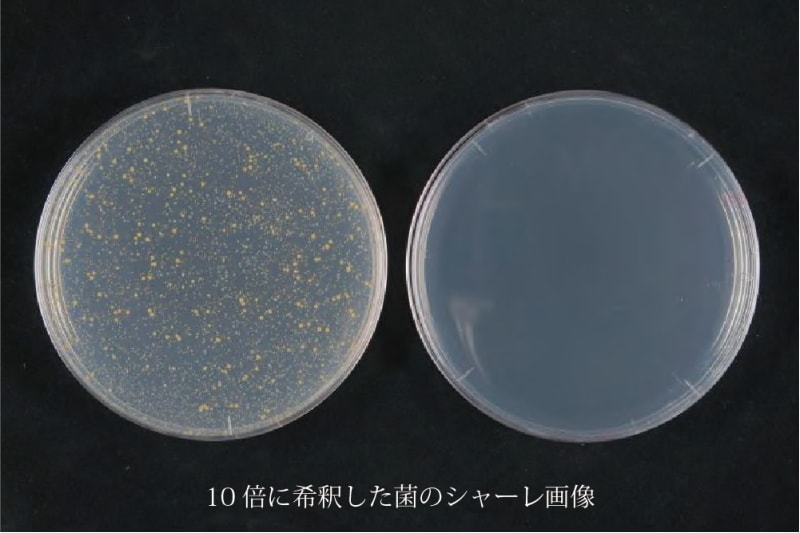

シーエンジの立体網状構造体(りったいあみじょうこうぞうたい)は、高速道路の分岐部や非常駐車帯に設置するための衝撃吸収材を日本道路公団(現NEXCO)と共同で開発を行っていた際に、衝撃吸収材の中材として誕生しました。
当時は素材に使用している樹脂の特性上、良い立体網状構造体はできないというのが世界の常識でした。
しかし、シーエンジ独自の技術力とノウハウで世界の常識を覆し、2000年から寝装品のクッション材としての販売を開始しています。
シーエンジのコンセプトは、「自然との共生」です。未来の子供たちが安心して暮らせる社会を残すことが我々の使命と考えています。
シーエンジの立体網状構造体は、すべて国内で製造されている安心安全な素材です。JIS基準試験や食品衛生法により素材の安全確認も行っています。
人にやさしく清潔に安心してお使いいただけます。
また、燃やしてもダイオキシン類が発生せず、マットレスの原料としてリサイクルが可能な環境にも優しい素材です。
立体網状構造体

立体網状構造体とは、糸状に押し出した樹脂が3次元的に絡み合った構造体です。
樹脂の種類や、サイズ、形状、硬さ、繊維の径などを調整することにより、様々なニーズにお応えすることが可能です。
製造特許
シーエンジは、国内および海外主要市場において立体網状構造体に関する特許を取得しています。
優れた特性と機能を生かし、寝装品に限らず様々な分野で活用されています。
【国内特許】
・特許第5986584号
「クッション、ソファ、ベッド等に使用する三次元網状構造体(ポリエチレン)」
・特許第61822249号
「三次元網状構造体マットレス(ポリエステル)」
【海外特許】
アメリカ、イギリス、ドイツ、フランス、オランダ、ポーランド
スウェーデン、トルコ、中国、インド、タイ、韓国
フィリピン、ベトナム、マレーシア、インドネシア、ロシア、ブラジル
使用原料
・ポリエチレン
・グリーンポリチレン(GRECO)
・再生ポリエチレン
・ポリエステルエラストマー
・ポリプロピレン

GRECO(グレコ)はバイオマスマークの識別表示に適合することが認定されています。
商品名 :GRECO(グレコ)
認定番号:220210
①ポリエチレンの特長
ポリエチレンは原油から生成される合成樹脂です。加工成形性が良く、軽量で防水性・耐薬品性に優れています。
・-20℃程度まで耐えうる耐寒性。
・吸水性がほとんどないため、防水性が高い。
・電気絶縁性が高く、電気を通さない。
・耐薬品性が高い。
・耐油性に優れる。
②ポリエステルエラストマーの特長
軟性と優れた耐久性を備えた熱可塑性ポリエステル・エラストマーです。一般的なプラスチックでは得られない柔軟性と、ゴムにはない物理的・化学的特性を兼ね備えています。
・機械的な強度が大きく、機械性能のバランスが良い。
・耐屈曲性に優れる。
・高温でも低温でも安定した性能を発揮できる。
・耐油、耐薬品性、耐オゾン性、(常温での) 耐水性。
・低温での柔軟性・耐屈曲性が優れる。
・優良な耐衝撃性、反発弾性をもつ。
・消音性能、摺動性が良く、耐磨耗性能も良い。
③ポリプロピレンの特長
ポリプロピレン(PP)も原油から生成される合成樹脂です。加工成形性が良く、軽量で防水性・耐薬品性に優れています。
・耐熱性、耐薬品性、機械的強度、絶縁性、断熱性に優れる。
・プラスチックの中では比重が小さい。
・表面光沢があり外観性が良く、硬度もある。
・ヒンジ特性、加工性、化学的・電気的特性が良い。
機能性素材
①難燃性
難燃剤を添加することで、難燃タイプの素材の生産が可能です。ポリエステル、ポリプロピレン、ポリエチレン共に難燃タイプの開発が可能です。
【難燃性能】
・UL-94 V 法:V-2 に適合
・FMVSS302:合格
・GB8410:合格
※難燃(なんねん)とは、材料が5分間「燃焼しない」「防火上有害な変形、溶融、き裂、その他の損傷を生じない」「避難上有害な煙又はガスを発生しない」ことをいいます。
②抗菌性
銀系無機抗菌剤をポリエチレンに添加することで素材に抗菌性を付与することが可能です。
対象の素材は、抗菌製品技術協議会のSIAAマークを取得しています。
※銀系無機抗菌剤は樹脂成型温度でも分解・変質がなく、有機溶媒等による溶出がなく、長期にわたり抗菌性を発現します。安全性の高い銀を有効成分としており、有機系の抗菌剤に比べ安全性、持続性、耐熱性等、多くの優位性を持っています。
③着色性
飾や識別、対候性の向上などを目的として素材に着色をすることが可能です。
成形時に樹脂の中に着色剤を混合することで着色を行ないます。外部着色とは異なり、色材を混ぜ合わせて着色を行うので、内部までムラがなく均等に着色を行うことができます。

加工技術
①熱成形加工
樹脂の持つ熱可塑性を利用し、任意の形に変形させることが可能です。高温槽の中で成形型で型押しすることで三次元的な形状に加工することができます。
最大寸法:(約)厚さ150×幅650×長さ850mm

②超音波加工
超音波振動により生じる摩擦熱で素材どうしを相互に融着する加工技術です。
縫い針により素材に貫通孔を開けるものと異なり針・縫い糸を使用していないため、糸切れや糸のほつれがありません。
素材同士や、素材と生地などを融着することが可能です。

③型抜き加工
属製の型で素材をプレスすることで、様々な形に加工ができます。
複雑な形状には向かない場合がありますが、金型に比べ比較的安価に抜き型が製作できるためコストを抑えることが可能です。


